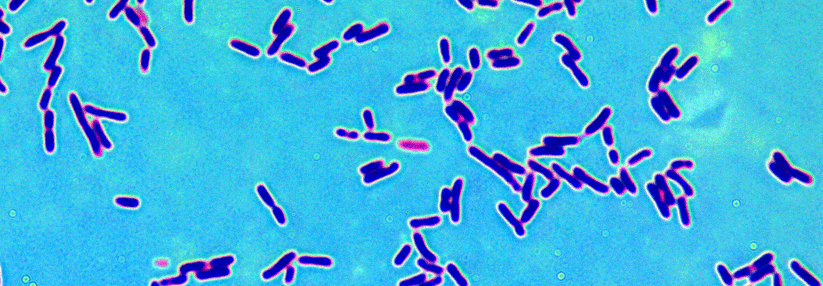

Spät, aber heftig
Wie Osteoporose an Männerknochen nagt
 Die Osteoporose lässt nicht nur Frauenknochen brechen, sondern auch die von Männern.
© Science Photo Library/Fung, K.H.
Die Osteoporose lässt nicht nur Frauenknochen brechen, sondern auch die von Männern.
© Science Photo Library/Fung, K.H.
Osteoporose ist keine Frauenkrankheit, betonte Professor Dr. Maria Luisa Brandi, Endokrinologische Abteilung der Medizinischen Klinik der Universität Florenz. Millionen von Männern leiden ebenso unter der Knochenschwäche und den Folgen der Brüche – insgesamt betreffen etwa 30 % der Hüftfrakturen Männer.
Männerknochen brechen später
Im Vergleich zu Frauen brechen ihre Knochen jedoch erst später: Ab einem Alter von etwa 60 Jahren steigen die Raten von Hüft-, Handgelenks- und Wirbelkörperfrakturen deutlich an. Weil Männer zum Zeitpunkt ihrer osteoporotischen Fraktur älter sind als Frauen, haben sie meist auch mit schwereren Folgen zu kämpfen. So zeigen Studien, dass 37 % der Männer das erste Jahr nach ihrer Hüftfraktur nicht überleben und bei den Übrigen die Lebensqualität deutlich reduziert ist.
Im Gegensatz zu den Frauen ist die Osteoporose bei Männern nur zu etwa einem Drittel primär, d.h., entweder idiopathisch oder altersbedingt. Die Mehrzahl der Fälle (65–70 %) ist sekundär. Mögliche Ursachen reichen von endokrinen Erkrankungen über Medikamente bis hin zu Lebensstilfaktoren (siehe Kasten). Zudem ergab eine Untersuchung aus dem Jahr 2016, dass neben Alter, vorangegangenen Frakturen und den schon bekannten Risikofaktoren noch weitere Umstände die Gefahr einer Hüftfraktur zusätzlich steigern können: Dazu gehörten z.B. eine hohe Statur, kognitive Einschränkungen, Scheidung und ein schlechtes Abschneiden im Aufstehtest.
Ursachen sekundärer Osteoporose bei Männern (Auswahl)
- endokrine Erkrankungen: Hypogonadismus, Cushing-Syndrom, Akromegalie, Diabetes, Vitamin-D-Mangel.
- Lebensstil: Alkoholmissbrauch, Bewegungsmangel, Rauchen, Unterernährung, Proteinmangel, Kalziummangel, Immobilisation.
- Medikamente: Glukokortikoide, Antiepileptika, Immunsuppressiva, Chemotherapeutika, HIV-Behandlung, Androgendeprivation.
- andere Erkrankungen: rheumatoide Arthritis, chronische Leber- oder Nierenerkrankungen, COPD, Plasmozytom, Malabsorptionssyndrome.
- Kalzium (Serum), Phosphat, Kreatinin, alkalische Phosphatase und Leukozyten
- Leberfunktionswerte
- Proteinelektrophorese bei über 50-Jährigen
- 25(OH)-Vitamin D und Parathormon
- Kreatinin und Kalzium im 24-Stunden-Urin
- Spezialtests je nach konkreten Hinweisen auf sekundäre Osteoporose.
Quelle: EULAR* 2021 Virtual Congress
* European Alliance for Rheumatology

















